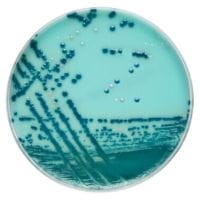
Brilliance_CRE_Agar_gotowa pożywka_do_oznaczania_Enterobacteriaceae_opornych_na_karbapenemy_(CRE)_bestlabs.jpg

Brilliance CRE Agar gotowa pożywka do oznaczania Enterobacteriaceae opornych na karbapenemy (CRE)
• Opakowanie: 10 szt.
• Płytka: 90 mm.
• Podłoże chromogenne.
• Do oznaczania Enterobacteriaceae opornych na karbapenemy (CRE).
• Wyrób medyczny: Tak.
 Opis
Opis
Brilliance CRE Agar to innowacyjne, gotowe podłoże chromogenne zaprojektowane do oznaczania Enterobacteriaceae opornych na karbapenemy (CRE). Produkt dedykowany jest do badań przesiewowych, umożliwiając szybkie i precyzyjne wykrywanie drobnoustrojów CRE, co wspiera efektywną kontrolę zakażeń w placówkach ochrony zdrowia.
Specyfikacja techniczna
- Opakowanie: 10 sztuk gotowych płytek.
- Wymiary płytek: 90 mm – standardowy rozmiar dostosowany do laboratoriów mikrobiologicznych.
- Rodzaj podłoża: Chromogenne, umożliwiające wizualne różnicowanie kolonii CRE.
- Zastosowanie: Wykrywanie Enterobacteriaceae opornych na karbapenemy w próbkach klinicznych oraz środowiskowych.
Cechy i zalety Brilliance CRE Agar
Precyzyjna identyfikacja Enterobacteriaceae opornych na karbapenemy
- Specjalnie opracowane wskaźniki chromogenne umożliwiają łatwe i szybkie wykrycie bakterii opornych na karbapenemy.
- Wysoka selektywność podłoża minimalizuje ryzyko wzrostu organizmów innych niż CRE, co gwarantuje dokładne wyniki diagnostyczne.
Gotowość do natychmiastowego użycia
- Fabrycznie przygotowane płytki eliminują potrzebę czasochłonnego przygotowywania podłoży w laboratorium.
- Standaryzowane parametry zapewniają powtarzalność wyników, zwiększając efektywność pracy diagnostycznej.
Wsparcie w kontroli zakażeń
Brilliance CRE Agar jest niezastąpionym narzędziem w monitorowaniu kolonizacji pacjentów oraz identyfikacji potencjalnych nosicieli CRE, co wspiera wdrażanie procedur zapobiegawczych w placówkach medycznych.
Dlaczego warto wybrać Brilliance CRE Agar?
Zaawansowana diagnostyka
Brilliance CRE Agar pozwala na precyzyjne różnicowanie kolonii bakterii opornych na karbapenemy, umożliwiając szybką reakcję na potencjalne zagrożenie epidemiologiczne.
Oszczędność czasu
Gotowe płytki pozwalają na natychmiastowe rozpoczęcie analizy, co znacząco skraca czas diagnostyczny.
Zgodność z międzynarodowymi normami
Produkt spełnia najwyższe standardy w diagnostyce mikrobiologicznej, zapewniając pewność i wiarygodność wyników.
Zastosowanie Brilliance CRE Agar
Kontrola zakażeń szpitalnych
Produkt znajduje zastosowanie w badaniach przesiewowych pacjentów hospitalizowanych, umożliwiając wykrycie nosicielstwa CRE i ograniczenie rozprzestrzeniania się opornych szczepów w placówkach ochrony zdrowia.
Diagnostyka laboratoryjna
Brilliance CRE Agar to narzędzie dedykowane laboratoriom mikrobiologicznym, zajmującym się wykrywaniem patogenów CRE w próbkach klinicznych i środowiskowych.
_________________________________________________________________________________________________________________________________________________________________________________________
Jest to wyrób medyczny.
Wyrób medyczny przeznaczony wyłącznie do użytku profesjonalnego, zgodnie z definicją zawartą w art. 2 pkt 1.26 Ustawy o wyrobach medycznych. Produkty te nie są przeznaczone do stosowania w warunkach domowych. Zakupu mogą dokonać jedynie osoby posiadające Prawo Wykonywania Zawodu (PWZ) lub firmy, podając numer NIP podczas składania zamówienia. W przypadku zamówienia złożonego przez użytkownika domowego, zostanie ono anulowane, a ewentualna wpłata zwrócona na konto klienta.
__________________________________________________________________________________________________________________________________________________________________________________________
W powyższym linku znajdą Państwo bazę aktualnych certyfikatów firmy OXOID. Wystarczy wpisać numer LOT zamówionej przez Państwa partii, w celu uzyskania odpowiedniego certyfikatu.
 Koszty dostawy
Cena netto, nie zawiera podatku
Koszty dostawy
Cena netto, nie zawiera podatku
darmowa i wygodna wysyłka
już od 800 zł netto
Najwyższa jakość
produktów potwierdzona certyfikatami
Zakupy 24h na dobę
wygodne i bezpieczne
bezpłatna konsultacja
z ekspertem online